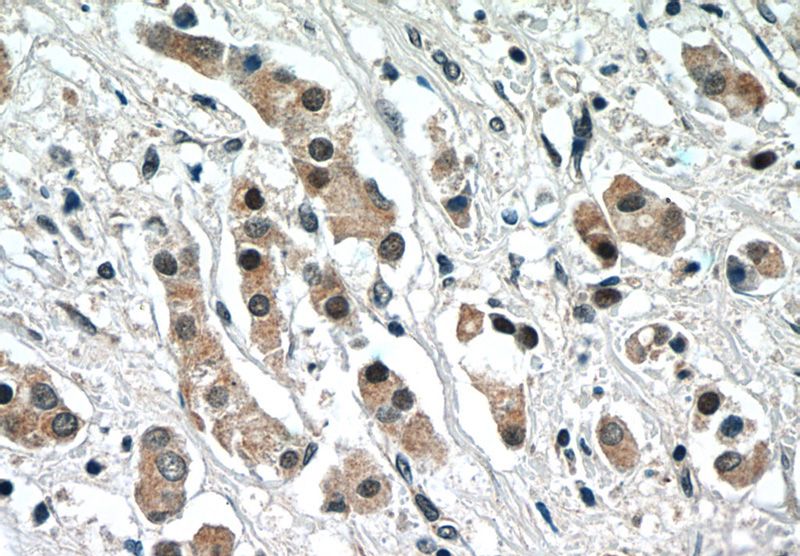
Immunohistochemistry of paraffin-embedded human breast cancer tissue slide using Catalog No:113277(NRF2, NFE2L2 Antibody) at dilution of 1:50 (under 40x lens)

-
Product Name
NRF2, NFE2L2 antibody
- Documents
-
Description
NRF2, NFE2L2 Rabbit Polyclonal antibody. Positive IHC detected in human breast cancer tissue, human colon cancer tissue, human kidney tissue, human liver cancer tissue, human ovary tumor tissue. Positive FC detected in MCF-7 cells. Positive WB detected in DMSO treated HeLa cells, MG132 HeLa cells. Positive IP detected in mouse kidney tissue. Observed molecular weight by Western-blot: 70-100 kDa
-
Tested applications
ELISA, WB, IHC, FC, IP
-
Species reactivity
Human, Mouse, Rat; other species not tested.
-
Alternative names
HEBP1 antibody; NF E2 related factor 2 antibody; NFE2 related factor 2 antibody; NFE2L2 antibody; NRF2 antibody
- Immunogen
-
Isotype
Rabbit IgG
-
Preparation
This antibody was obtained by immunization of NRF2, NFE2L2 recombinant protein (Accession Number: NM_006164). Purification method: Antigen affinity purified.
-
Clonality
Polyclonal
-
Formulation
PBS with 0.1% sodium azide and 50% glycerol pH 7.3.
-
Storage instructions
Store at -20℃. DO NOT ALIQUOT
-
Applications
Recommended Dilution:
WB: 1:200-1:2000
IP: 1:200-1:1000
IHC: 1:20-1:200
-
Validations

DMSO treated HeLa cells were subjected to SDS PAGE followed by western blot with Catalog No:113277(NRF2, NFE2L2 Antibody) at dilution of 1:600

IP Result of anti-NRF2, NFE2L2 (IP:Catalog No:113277, 3ug; Detection:Catalog No:113277 1:300) with mouse kidney tissue lysate 4000ug.
Immunohistochemistry of paraffin-embedded human breast cancer tissue slide using Catalog No:113277(NRF2, NFE2L2 Antibody) at dilution of 1:50 (under 40x lens)

1X10^6 MCF-7 cells were stained with 0.2ug NRF2, NFE2L2 antibody (Catalog No:113277, red) and control antibody (blue). Fixed with 90% MeOH blocked with 3% BSA (30 min). Alexa Fluor 488-congugated AffiniPure Goat Anti-Rabbit IgG(H+L) with dilution 1:1500.
-
Background
NRF2, also named as NFE2L2, belongs to the bZIP family and CNC subfamily. It is a transcription activator that binds to antioxidant response (ARE) elements in the promoter regions of target genes. NRF2 is important for the coordinated up-regulation of genes in response to oxidative stress. It may be involved in the transcriptional activation of genes of the beta-globin cluster by mediating enhancer activity of hypersensitive site 2 of the beta-globin locus control region.Nrf2 is a key player in the regulation of genes encoding for many antioxidative response enzymes.The expression of NRF2 may be induced under oxidative stress (PMID:14567983).In lung cancer, Nrf2 activation in malignant cells has been associated with tumor progression and chemotherapy resistance(PMID:20534738). Identifying patients with abnormal NRF2 expression may be important for selection for chemotherapy in NSCLC.
-
References
- Zhao F, Li K, Zhao L. Effect of Nrf2 on rat ovarian tissues against atrazine-induced anti-oxidative response. International journal of clinical and experimental pathology. 7(6):2780-9. 2014.
- Dong D, Qi Y, Xu L. Total saponins from Rosa laevigata Michx fruit attenuates hepatic steatosis induced by high-fat diet in rats. Food & function. 5(12):3065-75. 2014.
- Wang J, Zhang L, Zhang Y. Transcriptional upregulation centra of HO-1 by EGB via the MAPKs/Nrf2 pathway in mouse C2C12 myoblasts. Toxicology in vitro : an international journal published in association with BIBRA. 29(2):380-8. 2015.
- Su C, Zhang P, Song X. Tetrachlorobenzoquinone activates Nrf2 signaling by Keap1 cross-linking and ubiquitin translocation but not Keap1-Cullin3 complex dissociation. Chemical research in toxicology. 28(4):765-74. 2015.
- Su C, Xia X, Shi Q. Neohesperidin Dihydrochalcone versus CCl₄-Induced Hepatic Injury through Different Mechanisms: The Implication of Free Radical Scavenging and Nrf2 Activation. Journal of agricultural and food chemistry. 63(22):5468-75. 2015.
- Liu M, Xu L, Yin L. Potent effects of dioscin against obesity in mice. Scientific reports. 5:7973. 2015.
- Deng S, Tang S, Dai C. P21(Waf1/Cip1) plays a critical role in furazolidone-induced apoptosis in HepG2 cells through influencing the caspase-3 activation and ROS generation. Food and chemical toxicology : an international journal published for the British Industrial Biological Research Association. 88:1-12. 2016.
- Bai J, Jiang L, Qiu T. Taurine protects against As2O3-induced autophagy in pancreas of rat offsprings through Nrf2/Trx pathway. Biochimie. 2016.
Related Products / Services
Please note: All products are "FOR RESEARCH USE ONLY AND ARE NOT INTENDED FOR DIAGNOSTIC OR THERAPEUTIC USE"
